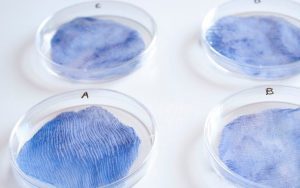
bacteria dying silk

Mandy Moore's Blog, page 11
September 19, 2018
WWW: Yarnporium Ticket Giveaway; Lotus Silk Weaving; Algae-based Textiles
 Yarnporium returns to London 2-3 November 2018 and is offering a pair of markethall tickets to one lucky Knitty Blog reader! This year’s show features even more makers and workshops, along with a yarn lovers lounge and talk series, all within the architectural splendor of Central Hall Westminster in the heart of central London. Teachers include our own Kate Atherley. Who, in addition to teaching is on a panel discussion about getting your independent pattern published, as part of the Makers Walking the Talk Series.
Yarnporium returns to London 2-3 November 2018 and is offering a pair of markethall tickets to one lucky Knitty Blog reader! This year’s show features even more makers and workshops, along with a yarn lovers lounge and talk series, all within the architectural splendor of Central Hall Westminster in the heart of central London. Teachers include our own Kate Atherley. Who, in addition to teaching is on a panel discussion about getting your independent pattern published, as part of the Makers Walking the Talk Series.
Our usual giveaway rules apply. Leave your comment below before midnight eastern time on Tuesday 25 September 2018 to be entered for a chance to win. One comment will be chosen at random to answer a skill testing question. If the commenter answers correctly they will win a pair of Yarnporium markethall entry tickets for 2 or 3 November 2018, valued at £10 each in advance (£12 at the door). Do we need to remind you this contest is only for markethall tickets? Ok, we just did. Winner is responsible for transportation and all other necessities to attend the event. Tickets are non-transferable.
 In Vietnam, weaver Phan Thi Thuan is working on an experiment, she is weaving fabric from lotus silk. It’s a labour intensive process, as 260 stems are required to produce about 175m of thread! The lotus silk creates a fabric with the distinctive aroma of the lotus blossoms. It will be interesting to see what happens in the future with this experiements!
In Vietnam, weaver Phan Thi Thuan is working on an experiment, she is weaving fabric from lotus silk. It’s a labour intensive process, as 260 stems are required to produce about 175m of thread! The lotus silk creates a fabric with the distinctive aroma of the lotus blossoms. It will be interesting to see what happens in the future with this experiements!
Continuing with the theme of new fibers, some designers are developing biodegradable textiles. These are created from algae, yeast, bacteria, and other sources. The goal is to reduce waste and pollution.
Continuing with the theme of new fibers, some designers are developing biodegradable textiles. These are created from algae, yeast, bacteria, and other sources. The goal is to reduce waste and pollution.
The post WWW: Yarnporium Ticket Giveaway; Lotus Silk Weaving; Algae-based Textiles appeared first on knittyBlog.

September 18, 2018
School of Sweet Georgia Discount for Knitty Readers
 Firelight on Yak/Silk. I’m trying very hard not to buy this and may fail……..photo by Felicia Lo
Firelight on Yak/Silk. I’m trying very hard not to buy this and may fail……..photo by Felicia LoHave you seen Felicia Lo’s wonderful School of Sweet Georgia lately? Felicia has recently launched School of Sweet Georgia version two and it is dynamite.
Instead of the standard “buy one class at a time” model, Felicia has created a immersive learning experience.
For an annual fee that’s less than $20 per month, you can learn the ins and outs of spinning, dyeing, knitting, and weaving with a focus on color, color, color.
In addition to deep dive video clases there are shorter mini workshops, live classes, a community forum, and a live Q&A monthly.
All of the information about the school can be found here.
Felicia is an expert dyer, spinner, knitter and weaver, and an excellent teacher. The videos are clear, easy to follow, and easy to learn from.So far, there are two classes on color theory: Colour Play and Colour Mastery and two classes on dyeing: Dyeing Intentional Colour and Dyeing Complex Colour. The newest class is Spinning from Scratch, a beginning spinning class. New content is added regularly, and Felicia is filming a new class as I write this.
More than anything the whole environment of the school is welcoming, beautiful and so very inspiring. It is a celebration of creativity and color.
Felicia is generously offering a discount on the annual membership fee to Knitty readers.
If you are interested in learning about color and fiber art in a supportive, enthusiastic, and knowledgeable environment the School of Sweet Georgia is the place you want to be.
The post School of Sweet Georgia Discount for Knitty Readers appeared first on knittyBlog.

September 12, 2018
WWW: accessible tartans, 3D weaving, exhibit on Filipino weaving
 Student Anna Cuinu has developed a tartan for the blind using stitch patterns, buttons, and belts to simulate the fabric.
Student Anna Cuinu has developed a tartan for the blind using stitch patterns, buttons, and belts to simulate the fabric.
 Looking to apply your fiber arts skills to other areas, such as weaving a fabric that can replace steel? Advances in the 3D technology for weaving and knitting of composite materials have created that reality. That’s only the start, 4D textiles are also in development, you can learn more at 3D Textiles: Embracing The Depth.
Looking to apply your fiber arts skills to other areas, such as weaving a fabric that can replace steel? Advances in the 3D technology for weaving and knitting of composite materials have created that reality. That’s only the start, 4D textiles are also in development, you can learn more at 3D Textiles: Embracing The Depth.
 If you are traveling to Honolulu, Hawaii in the next two months, visit the Hibla ng Lahing Filipino Traveling Exhibition. This exhibit of Filipino weaving also includes lectures, demonstrations, and workshops. It’s being shown from September 17 to November 17, 2018 at the University of Hawaii at Manoa.
If you are traveling to Honolulu, Hawaii in the next two months, visit the Hibla ng Lahing Filipino Traveling Exhibition. This exhibit of Filipino weaving also includes lectures, demonstrations, and workshops. It’s being shown from September 17 to November 17, 2018 at the University of Hawaii at Manoa.
The post WWW: accessible tartans, 3D weaving, exhibit on Filipino weaving appeared first on knittyBlog.

September 11, 2018
Three Movies to Watch While You Spin
 Ordeal by Innocence. Photo from Vanity Fair by James Fisher
Ordeal by Innocence. Photo from Vanity Fair by James Fisher
It’s time to start feathering your fall spinning nest. For me part of that is gathering things I want to watch (or binge) while I spin. I often invite friends over on the weekend and we have a movie afternoon. Spinzilla is coming up and these would be great to keep your wheel flying along. I recently watched all three of these and recommend them highly.
Do you love historical fiction and great costumes? Do you think that reading books can change your life?
The Guernsey Literary and Potato Peel Society (on Netflix) will thrill you. It’s based on the book of the same title, but i enjoyed it much more than the book. Tissues might be required.
If dysfunctional families and murder are more your (poisoned) cup of tea Agatha Christie’s Ordeal By Innocence (Amazon Prime) is so creepy and so good. This is the darkest take on an Agatha Christie I’ve ever watched. The cast, costumes and sets are stunning.
Are you like me and have never outgrown John Hughes movies? To All the Boys I’ve Loved Before (Netflix) has high school drama, unrequited crushes, impossibly good looking teens, and a happy ending. This movie is filled frothy goodness.
What have you watched lately that you’d recommend for a spinning afternoon?
The post Three Movies to Watch While You Spin appeared first on knittyBlog.

September 5, 2018
WWW: hacking a knitting machine; shawl library; share Farfield Mill
 Australian software engineer Sarah Spencer hacked a knitting machine to create an amazing stellar map.
Australian software engineer Sarah Spencer hacked a knitting machine to create an amazing stellar map.
It took over 100 hours to machine knit! The piece (worked over several panels) measures approximately 9 feet (2.8 meters) tall and 15 feet (4.6 m) wide and weighs about 33 pounds (15 kg).
 The Folger Shakespeare Library in Washington, D.C., lends handmade shawls to chilly researchers. (via @jillianmoreno)
The Folger Shakespeare Library in Washington, D.C., lends handmade shawls to chilly researchers. (via @jillianmoreno)
Which Which Knitty Shawl do you wish your library lent?
 Farfield Mill is the last working weaving mill in the Yorkshire Dales, in northern England. It is home to about 20 artisan businesses, the main retail outlet for around 60 arts and crafts producers; and venue for art and crafts exhibitions with a nationwide reputation. It also has a heritage centre featuring the history of wool and its impact on the local economy and landscape. It needs to secure its future and is converting to a Community Benefit Society to make that happen. Learn more and help support the future of this unique place.
Farfield Mill is the last working weaving mill in the Yorkshire Dales, in northern England. It is home to about 20 artisan businesses, the main retail outlet for around 60 arts and crafts producers; and venue for art and crafts exhibitions with a nationwide reputation. It also has a heritage centre featuring the history of wool and its impact on the local economy and landscape. It needs to secure its future and is converting to a Community Benefit Society to make that happen. Learn more and help support the future of this unique place.
The post WWW: hacking a knitting machine; shawl library; share Farfield Mill appeared first on knittyBlog.

September 4, 2018
What to Do with Fiber Slush
 My fiber slush after teaching
My fiber slush after teachingFiber slush is what I call all of the leftovers from spinning, the bits or lengths of unspun fiber that I can’t bring myself to just throw away.
Using fiber slush is a great opportunity to just play with fiber. It’s not fiber I’ve bought with anything specific in mind, so what I use it for is to stretch my creative spinning and color muscles.
I use it to make batts. Fiber slush is the perfect stuff to make heathered or tweed batts.
I use it on my blending board. Small bits of special shiny fibers really stand out in rolags and mini batts.
I use it to make oddball yarns, just grab fiber randomly and spin. Have you peeked in a yarn shop lately? Mishmash or patchwork yarns are very popular, and all they are are randomly marled yarns.
I use it to practice techniques, art yarn techniques, or worsted lace weight, I’m more likely to practice when the fiber I’m using isn’t something I might be saving for a project.
I use it to think about color, complete with notes, tags and samples in baggies. I feel freer somehow combining colors when they are smaller bits, I see combinations differently. I draft colors together, combine in plies, or just make my own patterned yarn.
What do you do with your fiber slush?
The post What to Do with Fiber Slush appeared first on knittyBlog.

August 29, 2018
WWW: Upcoming Fiber Festivals in Florida & New Mexico; Raising awareness of New Zealand’s wool industry; Knitted Poppies for Remembrance
 The Orlando Public Library is hosting a Fall Fiber Festival in celebration of Central Florida’s fiber arts scene. The daylong festival will take place on Sunday, September 30 from 2-4 p.m.
The Orlando Public Library is hosting a Fall Fiber Festival in celebration of Central Florida’s fiber arts scene. The daylong festival will take place on Sunday, September 30 from 2-4 p.m.
New Mexico’s Fall Fiber Fiesta 2018 is on Friday, Saturday, and Sunday November 16-18. This is the largest show in Santa Fe exclusively dedicated to handmade creations of New Mexico’s Fiber Artists.
 While New Zealand has a reputation as a sheep-loving nation, the country’s wool industry has been in a steady decline for many years. Locals are stripping off in an effort to revive the country’s national fibre and make wool sexy.
While New Zealand has a reputation as a sheep-loving nation, the country’s wool industry has been in a steady decline for many years. Locals are stripping off in an effort to revive the country’s national fibre and make wool sexy.
 Knitted poppy projects to commemorate 100 years since the end of World War One are growing. These projects include 5000 Poppies (Australia), the Victoria Park Poppy Project Ilkeston (England), Thetford (England), and more. Many of these projects are raising funds for the Royal British Legion and some are also seeking donations of knitted poppies.
Knitted poppy projects to commemorate 100 years since the end of World War One are growing. These projects include 5000 Poppies (Australia), the Victoria Park Poppy Project Ilkeston (England), Thetford (England), and more. Many of these projects are raising funds for the Royal British Legion and some are also seeking donations of knitted poppies.
If you see something such as a fiber festival you’d like to see featured in What’s What Wednesday, please let us know! There’s now a simple form to make your link submission easier. Thank you!
Patreons! We love you. A reminder — PLEASE if you’re contributing at a level that that sends you goodies in the post, log into your account and make sure your address is current and accurate. Last year there was a large pile of undeliverable mail and it made Amy (and Tully) sad. Being a Patron supports this magazine and allows us to continue to bring you free content. We want to say thank you. Remember, Patrons of all levels gain access to the private news feed which often features neat content not seen elsewhere.
The post WWW: Upcoming Fiber Festivals in Florida & New Mexico; Raising awareness of New Zealand’s wool industry; Knitted Poppies for Remembrance appeared first on knittyBlog.

August 28, 2018
Back to School Spinning
 Fall spun singles
Fall spun singlesHow do you celebrate back to school time?
If you have kids, there’s the relief of getting fall routines back. Maybe you can find the time for some extra spinning.
Everyone enjoys buying new school supplies, for spinners it may mean a new spinning journal or some new small tools.
Organization is in the air in the fall. I know I’m more of a fall cleaner and organizer than a spring cleaner.
Fall is a great time to set yourself up for your own learning. What spinning skills do you want to learn next? Will you take classes online, at a local shop or at a fiber show, or use books, magazines or the knowledge of your spinning tribe?
Now is the time to get ready for Spinzilla. Are you joining a team or spinning rogue? What will you spin?
A favorite of many spinners is making shopping lists ( and for some, shopping strategies) for the big fall fiber festivals.
School starts here after US Labor Day, and I have plans.
Since I work at home, I am adding spinning during lunch to my routine. I may add watching an episode of GLOW to that spinning lunch too.
I’ll be getting ready for fall teaching, organizing tools, samples and fiber. I even have a teaching fiber inventory system now (terrifying, but so useful). I’m already organizing my teaching for 2019 and have two gigs already booked for 2020.
I am making a very detailed shopping list for the fall. I’m teaching at shows and retreats that have great vendors, and spinning goodies, Wisconsin Sheep and Wool, Vermont Sheep and Wool, WEBS Spinning Summit, SAFF, and the Ross Farm’s Magical Fiber Fantasy Retreat at Disney World. I love to make plans for shopping, but usually when I get to a shop or marketplace I get very excited and buy all of the things.
I love how fall kicks my spinning, spinning thinking and spinning shopping into high gear.
How are you celebrating fall?
The post Back to School Spinning appeared first on knittyBlog.

August 22, 2018
WWW: Kristin Nicholas at Google; video of Eleanor Roosevelt knitting; a brief history of the tube sock
 Earlier this summer, Kristin Nicholas gave a talk at Google about “Crafting a Patterned Home” (see my review of her new book in our Spring+Summer 18 issue).
Earlier this summer, Kristin Nicholas gave a talk at Google about “Crafting a Patterned Home” (see my review of her new book in our Spring+Summer 18 issue).
It’s now up on YouTube, enjoy!
 The FDR Library (Presidential Library of Franklin Deleano Roosevelt) digitized and shared to YouTube 11 home movies including Eleanor Roosevelt knitting (begins at approx 2:25 of the first video).
The FDR Library (Presidential Library of Franklin Deleano Roosevelt) digitized and shared to YouTube 11 home movies including Eleanor Roosevelt knitting (begins at approx 2:25 of the first video).
What Knitty pattern do you think she’d knit?
A Brief History of the One-Size-Fits-All Tube Sock. To learn how to get your hand-knit socks to fit, please check out Custom Socks: Knit To Fit Your Feet by our Managing Technical Editor Kate Atherley.
The post WWW: Kristin Nicholas at Google; video of Eleanor Roosevelt knitting; a brief history of the tube sock appeared first on knittyBlog.

August 21, 2018
Handspun Summer Sachet
 This summer I challenged myself to make a quick handspun project that I could make while traveling, something portable, something useful.
This summer I challenged myself to make a quick handspun project that I could make while traveling, something portable, something useful.
I made a Summer Sachet. It needs two Schacht Zoom Loom squares, a bit of yarn for embroidering and sewing and a little dried lavender.
Zoom Loom squares only need 8 yards of yarn, quick to spin on a spindle. The stitching yarn uses even less yardage.
I used a braid of Lisa Souza’s gorgeous (and so soft) Superfine Merino in her South Pacific colorway. I spun and wove it as it came into a almost-worsted weight 2-ply for the square. For the embroidery, I broke out purple and green and spun them separately to stitch the lavender.
The directions for the Summer Sachet are on the Schacht Blog.
What did you make this summer?
The post Handspun Summer Sachet appeared first on knittyBlog.

Mandy Moore's Blog
- Mandy Moore's profile
- 6 followers



